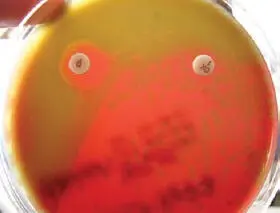

The selection of media to be used in isolation of pathogens from clinical specimens is dependent on several factors. First, the nutritional requirements of the specific pathogen must be met. For example, fastidious organisms require a medium that is enriched with specific nutrients, such as animal blood, serum, or other growth factors. If the clinical specimen is obtained from a site that has a resident microbiota, certain strategies will be necessary to isolate a specific pathogen from the accompanying resident microbiota. Often in this setting, a special type of medium called selective medium is used to recover these pathogens. This medium selects for the growth of a specific group of organisms. This is done by adding substances, such as dyes, antibiotics, or bile salts, that inhibit the growth of one group of organisms while permitting the growth of another. For example, MacConkey agar is a selective medium that contains bile salts and the dye crystal violet. These two substances are inhibitory for Gram-positive organisms as well as some Gram-negative ones. A wide variety of Gram-negative rods grow on this medium. Some selective media are also differential. MacConkey agar is an example of a selective and differential medium. The Gram-negative bacilli that grow on this agar can be differentiated from one another on the basis of the organism’s ability to ferment the carbohydrate lactose. Organisms that ferment lactose are called lactose positive, and organisms that are unable to ferment lactose are called lactose negative ( Fig. 10). When selecting media for culturing clinical specimens from sites with a resident microbiota, typically both enriched and selective media are used. If Gram-negative bacilli are a component of this microbiota, than a selective-differential medium might be used as well.

Figure 10
Certain organisms will not grow on media commonly used to culture clinical specimens, because the media may not be enriched enough or may contain inhibitory substances. When these organisms are sought, the laboratory must be notified so that special isolation medium can be used. Two important respiratory tract pathogens, B. pertussis and L. pneumophila , are examples of organisms that do not grow on standard laboratory media and require special media for their isolation.
Organism identification and susceptibility testing
Once organisms are isolated, they may be identified, and in some cases susceptibility testing needs to be performed. Bacteria and fungi grow as colonies on agar plates. The appearance of these colonies is often useful in determining the identity of the organism. Colonies may appear flat or raised, smooth or rough; may pit the agar; or may hemolyze red blood cells in blood-containing agar. Molds, for example, have very characteristic “fuzzy” growth on agar. Colonies of organisms such as S. aureus may be pigmented or may secrete a diffusible pigment, as seen with Pseudomonas aeruginosa . Skilled microbiologists often have a very good idea of the identification of a microorganism based solely on its colonial appearance.
In specimens that come from an area of the body with a resident microbiota, it is important to separate the colonies of organisms that may represent the resident microbiota from the colonies of organisms that may be pathogens. Much of the time, this can be done on the basis of colonial appearance. However, some potential pathogens, such as S. pneumoniae , a common cause of bacterial pneumonia, cannot be readily differentiated from viridans group streptococci, a member of the resident oropharyngeal microbiota. In patients with suspected bacterial pneumonia, a sputum specimen may be obtained. Sputum consists of secretions coughed up from the lower airways that are expectorated through the oropharynx and submitted for culture. Because they pass through the oropharynx, sputum specimens almost always contain viridans group streptococci. The appearance of colonies produced by viridans group streptococci is very similar to that produced by S. pneumoniae . To determine whether or not these colonies are S. pneumoniae , one must do tests based on the phenotypic characteristics of the organism; these are referred to as biochemicaltests. The biochemical test that is done most often to distinguish between these two organisms is the disk diffusion test, in which the organism’s susceptibility to the compound optochin is examined. S. pneumoniae ( Fig. 11) is susceptible to optochin, while the viridans group streptococci are not. On the basis of this easily performed test, the identity of S. pneumoniae can be determined from a sputum specimen.

Figure 11 Left disk, optochin; right disk, oxacillin.
Bacteria are typically identified on the basis of colonial morphology, Gram stain reaction, the primary isolation media on which the organism is growing, and biochemical and serologic tests of various degrees of complexity. Figures 12and 13are flow charts that give fairly simple means of distinguishing commonly encountered human pathogens. Yeasts are identified in much the same way that bacteria are, while molds are generally identified on the basis of the arrangement of microscopic reproductive structures called conidia. It is important to accurately identify bacteria and fungi because certain organisms (e.g., B. pertussis ) are the cause of certain clinical syndromes (in this case, whooping cough). Other bacteria (e.g., Staphylococcus epidermidis ) may represent contamination in a clinical specimen (e.g., a wound culture). The accurate identification of a bacterium or fungus may help determine what role a particular microbe may be having in the patient’s disease process.
Antimicrobial susceptibility typically is performed on rapidly growing bacteria if the organism is believed to play a role in the patient’s illness and if the profile of antimicrobial agents to which the organism is susceptible is not predictable. Let’s take three clinical scenarios to explain this concept.
First, a patient with a “strep throat” has group A streptococci recovered from his throat. Although the organism is clearly playing a role in the illness of this patient, antimicrobial susceptibility testing is not warranted. This organism is uniformly susceptible to first-line therapy—penicillin—and is susceptible more than 98% of the time to second-line therapy—the macrolide antibiotics such as erythromycin—although recent reports suggest that erythromycin resistance is becoming more frequent in this organism.
Second, a patient presents with a leg abscess from which S. aureus is recovered. Susceptibility testing is indicated because some strains are resistant to the first-line drugs used to treat this infection—semisynthetic penicillins, including oxacillin and dicloxacillin—and the second-line drug, clindamycin. In this situation, the patient may be started on empiricantimicrobial therapy until the susceptibility of the organism is known. If the organism is resistant to the agent used for empiric therapy, then the patient should be treated with an alternative antimicrobial agent to which the organism is susceptible.

Figure 12
Читать дальше